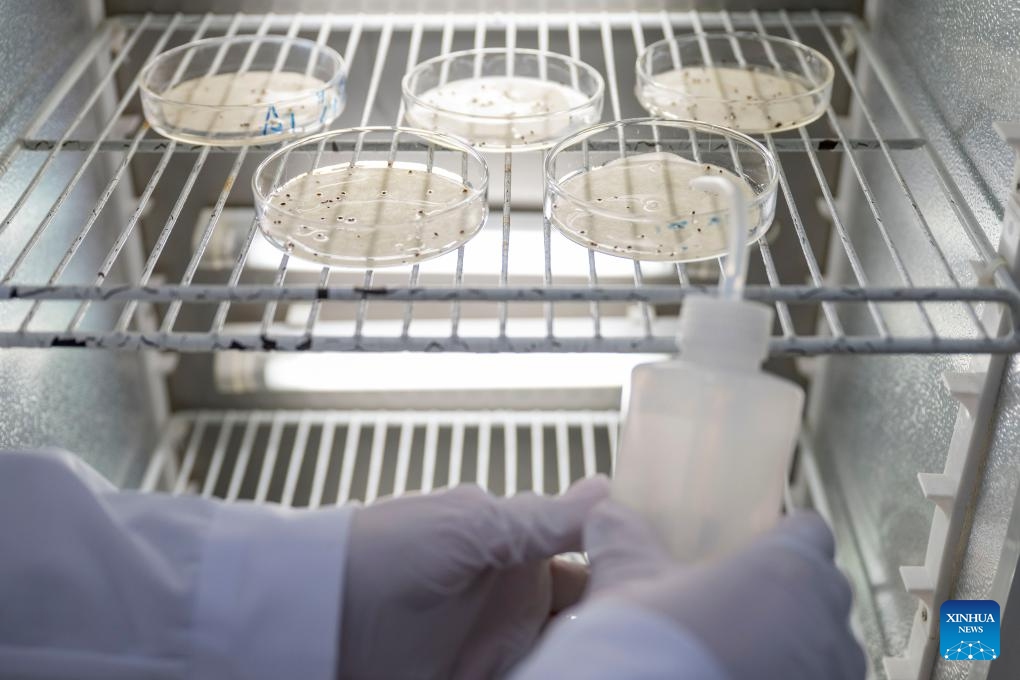
A staff member checks the condition of cranberry seeds at a cranberry R&D center in Fuyuan City, northeast China's Heilongjiang Province, Nov. 6, 2025. (Xinhua/Zhang Tao)

Boxes of cranberries are seen at a cranberry planting base in Fuyuan City, northeast China's Heilongjiang Province, Sept. 26, 2025. Located in the easternmost of China's land territory, Fuyuan City boasts of an ideal environment and ecosystem for cranberry cultivation. (Photo by Han Rui/Xinhua)

Staff members check the growth of cranberry seedlings at a cranberry R&D center in Fuyuan City, northeast China's Heilongjiang Province, Nov. 6, 2025. (Xinhua/Zhang Tao)
A staff member checks the condition of cranberry seeds at a cranberry R&D center in Fuyuan City, northeast China's Heilongjiang Province, Nov. 6, 2025. (Xinhua/Zhang Tao)

A staff member packs cranberries at a cranberry workshop in Fuyuan City, northeast China's Heilongjiang Province, Nov. 6, 2025. (Xinhua/Zhang Tao)

An aerial drone photo taken on Nov. 6, 2025 shows a staff member harvesting cranberries at a cranberry planting base in Fuyuan City, northeast China's Heilongjiang Province. (Xinhua/Zhang Tao)